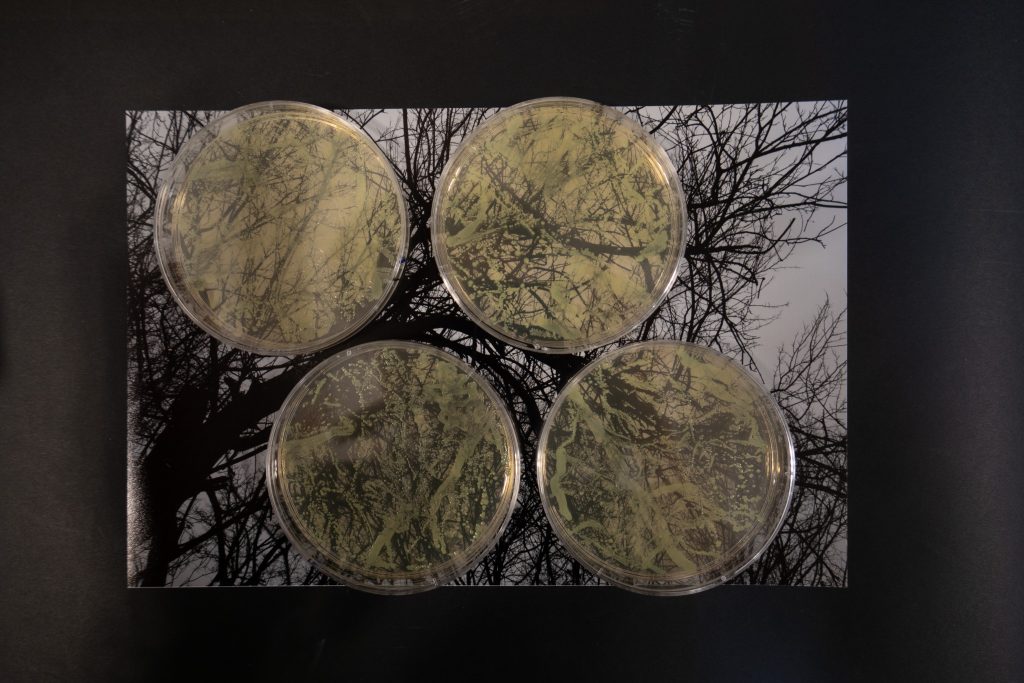
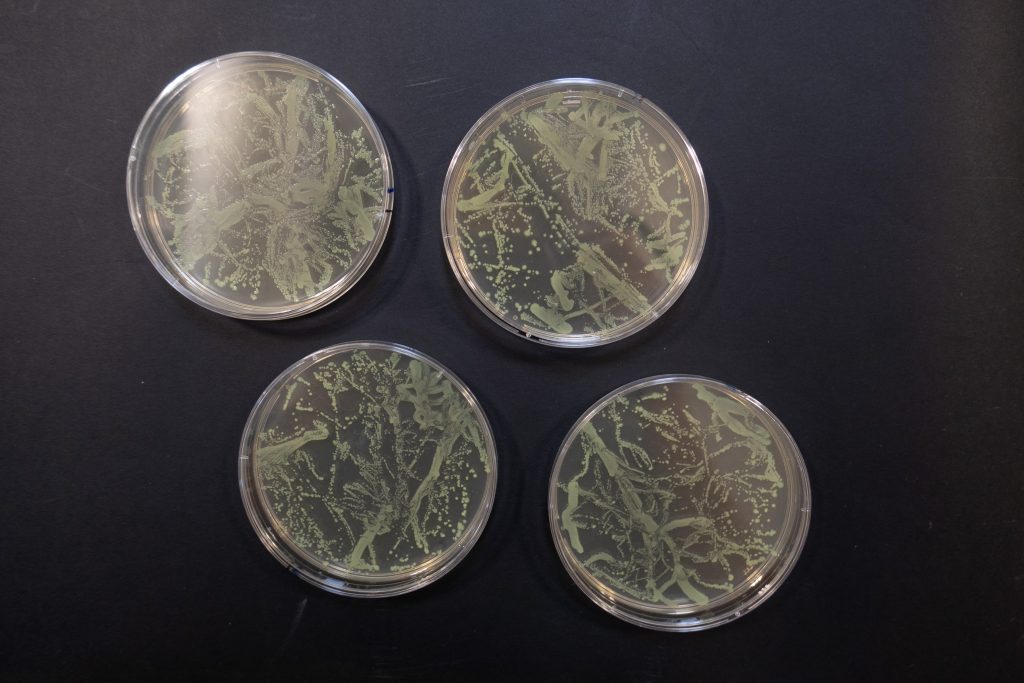
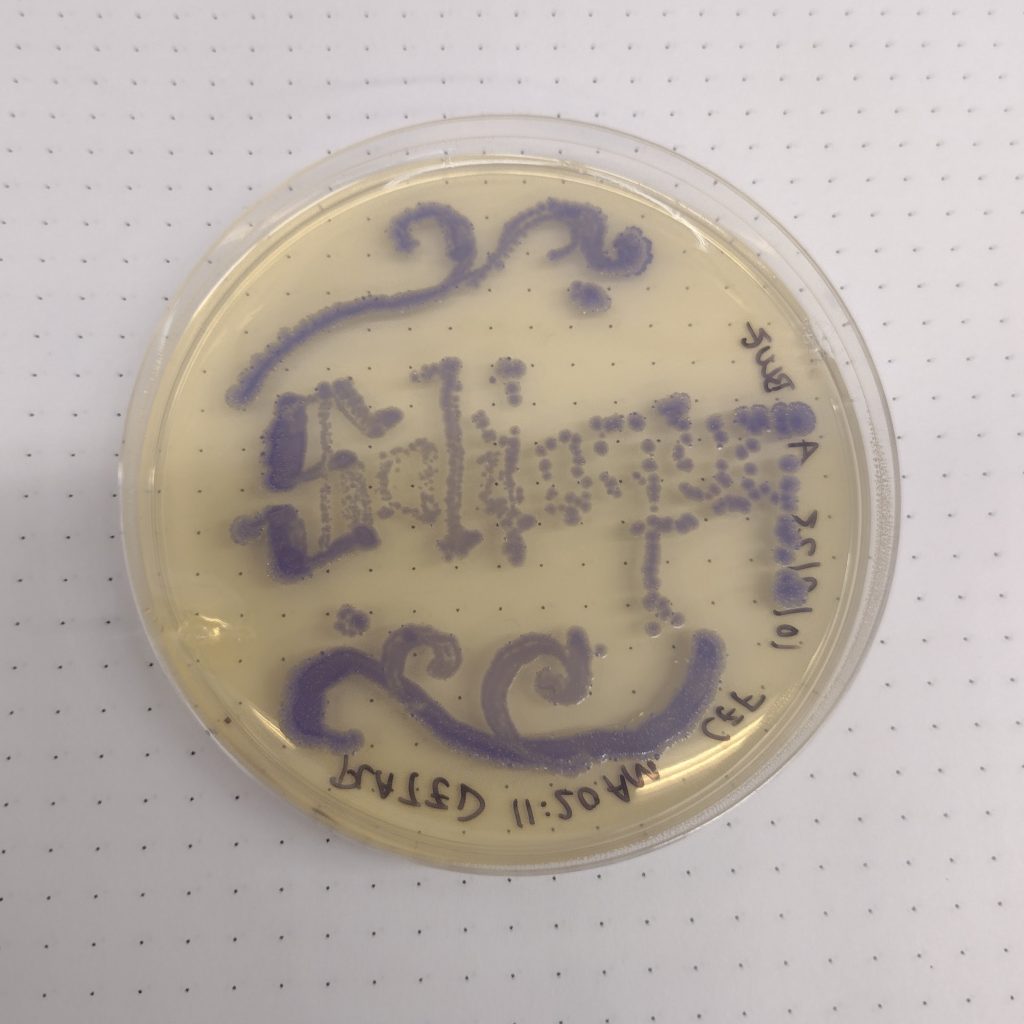
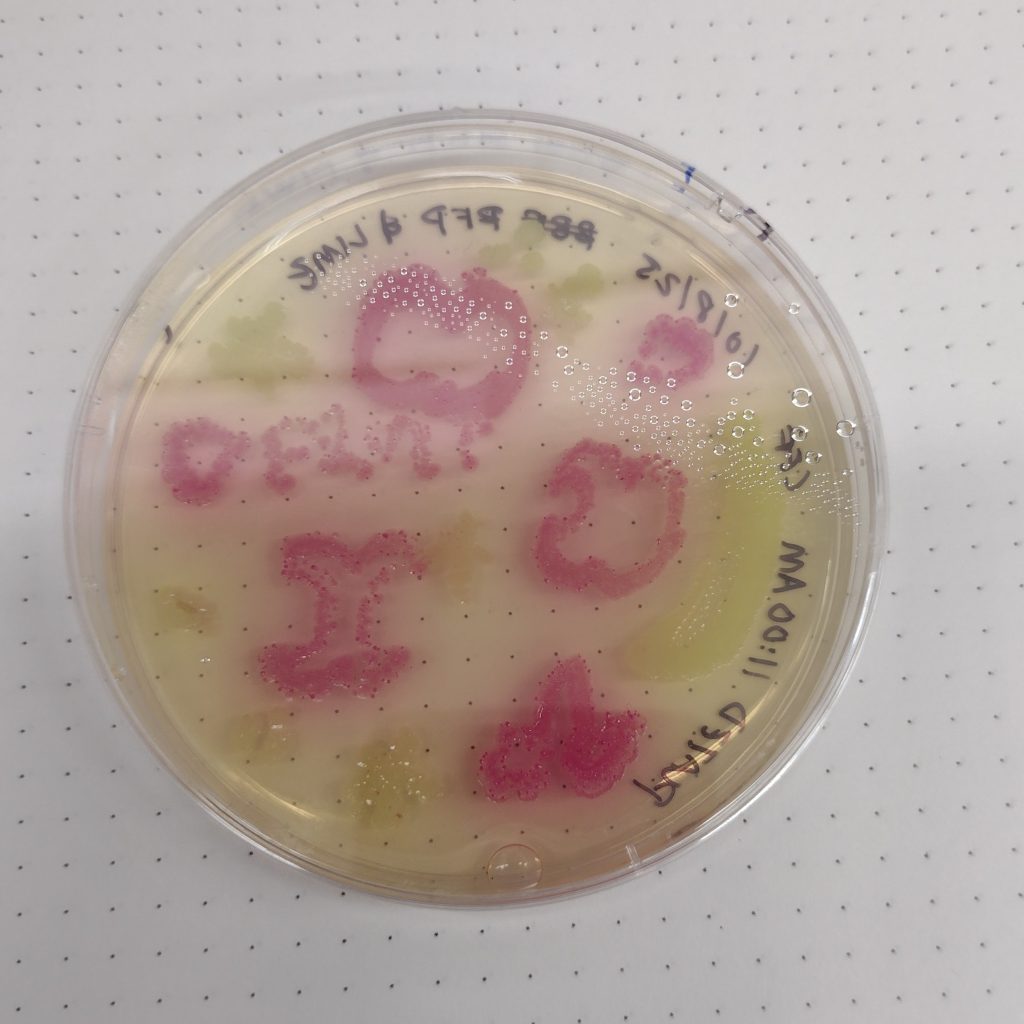
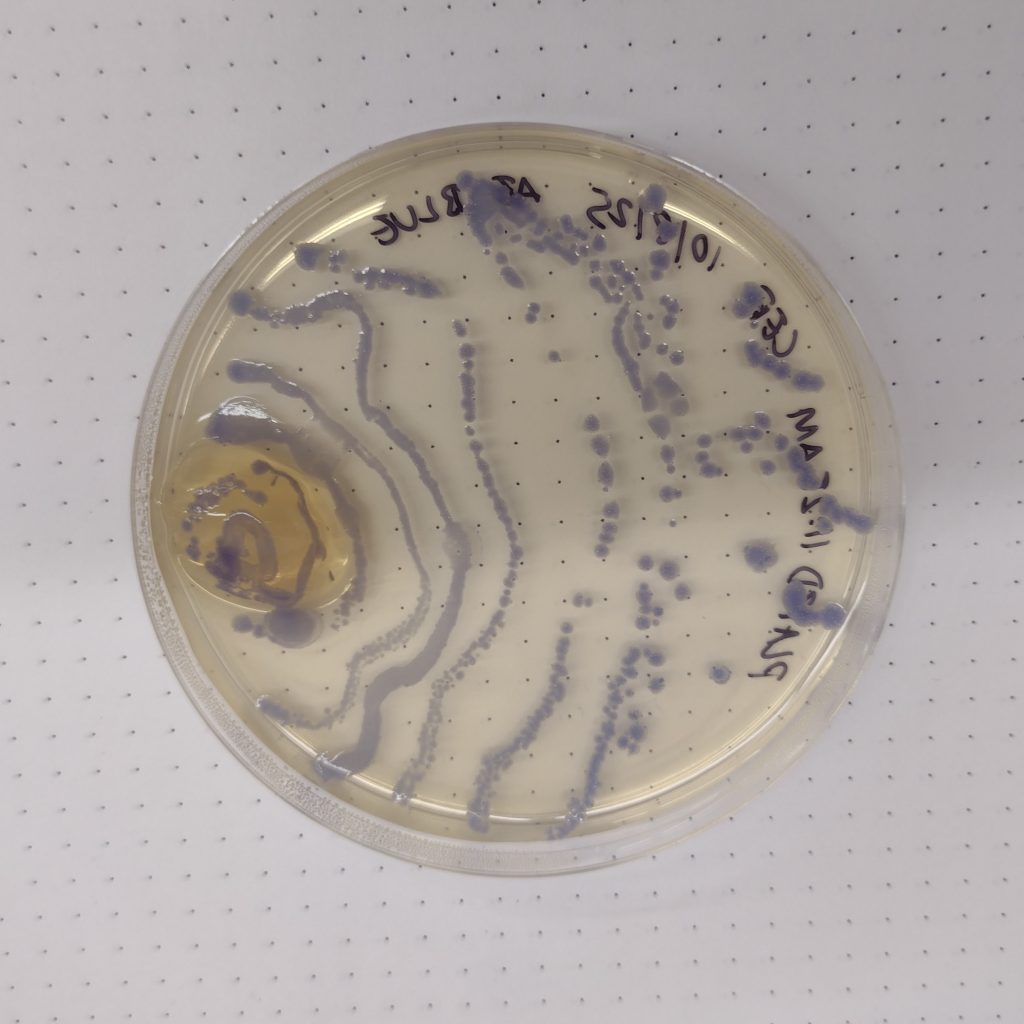

CECIL ESTEVES FREIRE, ESJ/HUMANISTIC STUDIES, 2027
Hello… I like food and funny things. I also like taking pictures of tree branches in the winter.
Project Overview
So my first idea (if you’ve seen my other 2 projects, this will make sense) was to make a little cake out of 3 layers of agar with little dots of different colors on each layer, and to de-mold them and stack them to make a messed up mini funfetti cake. This was unrealistic and also kind of boring so I went with idea number 2, building on concepts that I like thinking about when I take photos (my photography work is quite different aesthetically from my other kinds of work). My absolute favorite thing to photograph is tree branches in the winter when you can really see them twisting and tangling and get a sense of the structure of the tree. It kind of looks like veins, but also like other things in nature like corals, hyphae and mycelial networks, slime molds, etc. So the goal here was for the bacteria to mimic my lines mimicking trees mimicking other kinds of like in a mini display of interspecies connectivity. (It makes my head hurt to think about.)

Process
I took the photos in the winter/spring of 2025 with a Panasonic Lumix LX100II. All I did was place the plates over the photos and trace to the best of my ability. It was difficult to tell where I had already traced and where I hadn’t which is what led to the lines being all wonky and weird. I used the blue plastic loop tool and the lime liquid culture that Zander prepped (thanks Zander!!!). I chose lime because I liked the color, aesthetically, but also because trees -> green -> lime. Although I think a more reflective/glowing color would also be really cool.
I initially had thought that this would look really cool if I used a stencil because the halftone effect looked so awesome on the computer but I’m not a tech wizard and even though I figured out how to set up the file in Grasshopper, the rest of that process was so genuinely confusing that I decided to pivot. Plus, drawing it was pretty fun and felt more reflective of the concepts I wanted to portray.
I displayed my 4 plates on a print of one of my photos. It’s the standard glossy paper from the photo lab, and then black paper underneath.
Below are some tests. Some of my agar plates came out lumpy, as you can see on the far right. Colors used for the tests were blue, RFP/red, and lime.

Learn More
Here’s my contact just in case:
cestevesfreire@gmail.com (I actually check my email)
cestevesfreire@mica.edu
@dozingggreen on Instagram